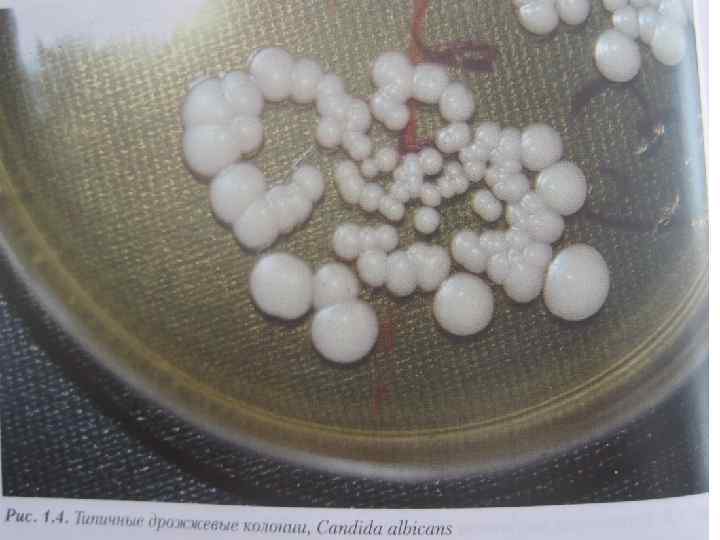

возбудители грибковых инфекций.ppt
- Количество слайдов: 49

Общая и частная микология. Патогенные грибы.

Мир микробов Представители Уровень организации Размер, мкм Число генов Распространение в природе Доклеточные Прионы (инфекционные белки) Вироиды (ДНК, РНК) Вирусы Макромолекул ы Частицы 0, 1 – 0, 3 1 (хозяина) 1 – 100 я 0, 01 – 0, 4 До 100 Только в живом организме (внутриклеточные паразиты) До 5000 До 10000 В живой и неживой природе Клеточные Бактерии Грибы Простейшие Прокариоты Эукариоты 1 – 10 1 – 30 10 - 50

я

• Грибы-много-или одноклеточные нефотосинтезирующие(бесхлорофильные) эукариотические микроорганизмы с толстой клеточной стенкой. • Грибы- имеют ядро, цитоплазму с органеллами, цитоплазматическую мембрану и мощную клеточную стенку, состоящую из нескольких типов полисахаридов белков и липидов. • Грибы- размножаются половым( с образованием гамет, половых спор) и бесполым(вегетативным)с бразованием бесполых спор, почкованием и фрагментацией гиф-способами

• • Царство грибов насчитывается свыше 100000 видов, объединенных в 7 классов, которые в свою очередь подразделяются на подклассы, порядки, семейства, роды, виды и штаммы. Среди них встречаются сапрофиты, паразиты и факультативные паразиты растений, животных и человека. Царство настоящих грибов Eumycota включает четыре типа грибов, имеющих медицинское значение: зигомицеты-Zygomycota аскомицеты-Fscomycota базидиомицеты-Basidiomycota дейтериомицеты-Deiteromycota

Различают совершенные и несовершенные грибы. Совершенные грибы имеют половой способ размножения; к ним относятся: • зигомицеты(Mucor, Rhizopus) • аскомицеты(Aspergillus, Penicillium, дрожжи) • базидиомицеты(шляпочные съедобные и ядовитые грибы. Несовершенные грибы имеют бесполый способ размножения; к ним относятся: • дейтериомицеты(дрожжеподобные грибы рода Candida)

• Различают два основных типа грибов • дрожжевые грибы(овальные клетки) • гифальные (плесневые) грибы образуют ветвящиеся тонкие нити-гифы, сплетающиеся в грибницу-мицелийплесень • Гифы низших грибов не имеют перегородок, у высших – гифы разделены перегородкамисептами с отверстиями

Строение грибов Грибы Низшие Высшие Одноклеточные организмы. Многоклеточные организмы. Тело образовано одним разросшимся гифом Размножаются почкованием. тело разделено перегородками (септиями) на отдельные гифы. Размножаются половым и бесполым путем.

Спорангий Спорангиеносец Строение низших грибов (Mucor)

Дочерняя клетка Клеточная стенка Ядро Цитоплазма Строение дрожжей.

Стеригмы Конидии Конидиеносец Гифы Строение высших грибов (Aspergillus и Penicillium).

Формы грибов Дрожжевая (овальные клетки) Мицелиальная (плесневая) Мицелиальные грибы построены из длинных тонких нитей (гиф). Гифы низших грибов не имеют перегородок, у высших – гифы разделены перегородками. Грибы, размножающиеся спорами половым и бесполым путем, относятся к совершенным. Несовершенные – те, у которых отсутствует или еще не описан половой путь размножения. Кроме этого существует также вегетативный путь размножения (почкование).

Симптомы грибковых инфекций: Грибковые инфекций могут поражать различные органы. При этом симптомы могут существенно различаться, что зависит от пораженных органов и вида грибка.

Возбудители грибковых кишечных инфекций • Микотоксикозы - пищевые отравления человека и животных, вызываемые микотоксинами - продуктами жизнедеятельности грибов, образующимися при их росте на пищевых продуктах и пищевом сыръе. • Микотоксины продуцируются многими фитопатогенными и сапрофитными грибами • Токсинообразующие грибы широко распространены в почве. Продуцируемые ими микотоксины накапливаются в сельскохозяйственных культурах и продуктах питания при неблагоприятных условиях сбора, хранения и обработки. • Одним из распространенных микотоксикозов являются фузариотоксикозы:

• Споротрихиеллотоксикоз тяжелое заболевание, связанное с действием микотоксинов гриба Fusarium sporotrichiella. Гриб развивается на зерновых культурах, перезимовавших под снегом или при позднем сборе урожая зерновых. • Фузариограминеаротоксикоз (синдром «пьяного хлеба» ) – заболевание , возникающее в результате употребления выпеченных изделии из зерна, пораженного Fusarium graminearum. При этом возникает слабость, скованность походки, резкие головные боли, головокружение, рвота, диарея, боли в животе.

• Фузарионивалетоксикоз возникает при употреблении продуктов питания из пшеницы, ячменя и риса, зараженных « красной плесенью» – грибами рода Fusarium (F. graminearum, F. nivale, F. avenaceum). Эти грибы продуцируют микотоксины. Отравление вызывает рвоту, диарею, головные боли, конвульсии. • Сердечная форма синдрома бери – бери - заболевание, известное с 1700 г. в Японии, возникающее в результате употребления в пищу желтоокрашенного риса, сорго, зараженных Penicillium citreoviridae, P. islandicum. Микотоксин поражает центральную нервную и сердечно – сосудистую систему. Возможен смертельный исход.

• Эрготизм – заболевание, возникающее при употреблении злаковых, пораженных рожками спорыньи –Claviceps purpurea и Claviceps paspalum. Поражаются люди и животные. Острая форма характеризуется высокой летальностью. У больных возникают симптомы острого гастроэнтерита и поражения центральной нервной системы. • Афлатоксикозы - заболевания, возникающие при употреблении продуктов питания /зерновые, арахис, морковь, фасоль, какао/, которые содержат афлатоксины, продуцируемые Aspergillus flavus и Aspergillus parasiticus. Они не разрушаются при термической обработке. Следует отметить исключительно высокую токсичность афлатоксинов.

Заболевание Возбудители Споротрихиеллотоксикоз (алиментарнотоксическая алейкия) Fusarium sporotrichioides Хлеб, выпеченный из пораженного зерна Гранулоцитопения, некроз костного мозга, нарушение кроветворения Фузариограминеартоксикоз Fusarium graminearum Хлеб, выпеченный из пораженного зерна Поражение ЦНС, слабость, скованность походки, резкие головные боли, головокружение, рвота, диарея, боли в животе и психические расстройства Фузарионивалетоксикоз Fusarium graminearum, Fusarium avenaceum Продукты питания из пшеницы, ячменя и риса, зараженные красной плесенью Рвота, диарея, головные боли, конвульсии Сердечная форма синдрома бери Penicillium citreoviridae, -бери Penicillium islandicum Источники заражения Клиническая картина Желтоокрашенный Поражения ЦНС ( «желтушный» ) рис, сорго (нисходящие параличи), сердечно-сосудистой системы, печени. Возможен летальный исход

Заболевание Эрготизм Возбудители Источники заражения Клиническая картина С 1 avuiceps purpurea, C 1 avuiceps paspalum Злаковые (чаще рожь), пораженные рожками спорыньи Острая форма – острый гастроэнтерит, поражение ЦНС (парастезии, судороги), высокая летальность. Хроническая форма – ощущение ползания мурашек (особенно на конечностях), рвота, желудочнокишечные расстройства Афлатоксикоз Aspergillus flavus, Aspergillus parasticus Растительные продукты питания (зерновые, арахис, морковь, фасоль) Вялость движений, судороги, парезы, геморрагии, отеки, нарушения функций ЖКТ, поражение печени (некроз, цирроз, первичный рак) Стахиботриотоксикоз Stachybotrys alternans Контакт с зараженным кормом для лошадей, крупного рогатого скота, домашней птицы Дерматиты, пневмокониозы

Возбудители грибковых респираторных инфекций • К респираторным грибковым инфекциям относятся плесневый микоз ( аспергиллез, пенициллиноз, мукороз), некоторые глубокие микозы ( кокцидиоидоз, гистоплазмоз), пневмоцистозная пневмония и пневмомикотоксикозы. • Плесневые микозы наиболее часто встречаются у работников пивоваренных заводов, имеющих контакт с заплесневелым зерном, у грузчиков зерновых культур, мукомолов, рабочих силикатной промышленности, работников фармацевтических производств, откормщиков голубей.

• Аспергиллез. Основной возбудитель аспергиллеза – Aspergillus fumigatus – плесневый грибок с септированными гифами. Аспергиллы распространены в окружающей среде повсеместно: растут на опавших листьях, в хранящемся зерне, в компосте, сене и других продуктах растительного происхождения, подверженных гниению. • Вдыхание спор гриба происходит чрезвычайно часто, однако болезнь развивается редко. Инфицирование легочной ткани характерно только для больных с иммунодефицитом.

• Мукороз. Основными этиологическими агентами мукороза служат Rhizopus и Mucor – грибы с несептированным мицелием, которые распространены повсеместно, обнаруживаются в гниющих растительных остатках , навозе, продуктах с высоким содержанием сахара. • Лабораторная диагностика включает микроскопию исследуемого материала, посев его для выделения чистой культуры возбудителя, выявления антител в сыворотке крови больных, постановка кожно – аллергических проб, заражение морских свинок и кроликов. • Специфическая профилактика не разработана.

• Адиаспиромикоз – хронический микоз, характеризующийся преимущественным поражением лёгких. Возбудители – Emmonsia crescens и E. parva – двухфазные грибы. Больной человек не опасен для окружающих. Заболевание может протекать по типу туберкулёза, аллергического альвеолита с гниениями лёгочной недостаточности. Кокцидиоидоз. Возбудитель – Coccidioides immites. Это эндемический системный микоз с преимущественным поражением дыхательных путей. Источником инфекций служит почва. Больной человек не заразен для окружающих.

• Гистоплазмоз – глубокий микоз, характеризующийся преимущественным поражением дыхательных путей. Возбудители – Histoplasma capsulatum и H. duboisii. Источником инфекций является почва. Больной человек не заразен. • Бластомикоз- это хронический микоз, первично поражающий лёгкие. Возбудитель – Blastomycer dermatitidis. Больные не заразны. Первичные очаги воспаления развиваются в лёгких. • Лабораторная диагностика. Исследуют мокроту, гной, слизистых оболочек носа и ротовой полости, лёгочную ткань. Для диагностики используют микроскопический, микологический, серологический. • Лечение. Антимикотики. • Специфическая профилактика не разработана.

• Пневмоцистоз. Болезнь относится к оппортунистическим микозам. Возбудителем является Pneumocystis carinii. Гриб обнаруживается в лёгочной ткани. У больных СПИДом пневмоцистозная пневмония развивается в 80 % случаев. • Лабораторная диагностика. Проводят микроскопию патологического материала. Для окраски применяют метод Романовского – Гимзы. Для серологической диагностики используют определение антител с помощью РИФ и ИФА. • Лечение. Ко-тримоксазол. • Специфическая профилактика не разработана.

• Кокцидиоидоз. Возбудитель – Coccidioides immites. Это эндемический системный микоз с преимущественным поражением дыхательных путей. Источником инфекций служит почва. Больной человек не заразен для окружающих. Восприимчивость населения всеобщая.

Кожные грибковые инфекции: Грибковые инфекции могут возникать на любом участке кожи: на туловище, руках и ногах. На лице и волосистой части головы, в паху, на подошве стоп, между пальцами. На коже грибки зачастую растут изнутри наружу. Из-за грибков кожа выглядит потрескавшейся и раздраженной. Поэтому грибковая инфекция часто имеет вид красного округлого пятна, также известного под названием «лишай» . Известно, что грибки вызывают возникновение многих кожных инфекций. Однако есть несколько заболеваний, которые требуют особого внимания при диагностике и лечении, так как возникают при наличии нескольких определенных факторов и могут являться последствием грибковой инфекции и бактериальной инфекции одновременно.

Возбудители грибковых кожных инфекций Среди грибов, поражающих наружные покровы, выделяют кератомицеты и дерматомицеты. • Кератомицеты малоконтагиозны. Они поражают поверхностные отделы рогового слоя эпидермиса, вызывая кератомикоз. Так дрожжеподобные грибы рода Malasseria вызывают отрубевидный лишай, характеризующийся появлением на коже туловища и шеи человека розовато – желтых невоспалительных пятен. При соскабливании на пятнах появляются чешуйки, похожие на отруби.

• Дерматомицеты –патогенные грибы, высококонтагиозны; заражение происходит контактным путём от больных людей, при посещений бани и бассейна, при контакте с больными животными. Грибы поражают кожу и её придатки – ногти и волосы, вызывая дерматомикозы. • Трихофития /стригущий лишай/ вызывается грибами рода Trychophyton. При поверхностной трихофитии поражается кожа; она воспаляется, шелушится. Волосы надламываются у поверхности кожи. При инфильтративно – нагноительной трихофитии в коже развиваются абсцессы и гранулемы, пораженные волосы выпадают.

• Микроспория /стригущий лишай/– высококонтагиозное заболевание ( в основном у детей). Возбудитель Microsporum canis вызывает заболевание у кошек, собак и человека. Возбудитель антропонозной микроспории Microsporum ferrugineum поражает только человека; наблюдается изменение кожи и волос. Вокруг волос образуются «муфты» или «чехлы» из мелких спор, волосы ломаются. • Фавус /парша/– хроническое заболевание, вызываемое Trichophyton schoenleinii. Поражаются кожа, волосы и ногти. Характерно образование скутулы – скопление спор, мицелия, клеток эпидермиса и жира.

• Эпидермофития вызывается грибом Epidermophyton floccosum, эпидермофития стоп – грибом Trichophyton interdigitalis. Поражаются складки кожи и ногти, волосы не поражаются. • Заболевание наружных покровов вызывают также условнопатогенные грибы рода Candida, «плесневые» грибы родов Penicillium, Aspergillus и Mucor после длительной антибактериальной химиотерапии и снижения иммунного статуса. • Грибы рода Candida в небольшом количестве входят в состав нормальной микрофлоры человека, но при определенных условиях, таких как дисбиоз и иммунодефицит, вызывают кандидамикоз. При поверхностных кандидомикозах появляются белые налеты «молочница» , красные пятна, визикулы.

Антропофильные дерматофиты Виды дерматофитов Микозы Microsporum audouinii, M. ferrugineum Trichophyton tonsurans, T. violaceum Микроскопория Trichophyton mentagrophytes var. interdigitale Epidermophyton floccosum Эпидермофития стоп, ногтей (онихомикоз) Эпидермофития паховая, ногтей (онихомикоз) Руброфития стоп, ногтей (онихомикоз) Фавус Trichophyton rubrum Trichophyton schoenleinii Трихофития

Зоофильные дерматофиты Виды дерматофитов Природный резервуар Микозы Microsporum canis Кошки, собаки, лошади Микроспория Microsporum gallinae Домашняя птица Микроспория Microsporum nanum Свинья Микроспория Trichophyton verrucosum Крупный рогатый скот Трихофития Trichophyton equinum Лошади Трихофития Trichophyton mentagrophytes var. mentagrophytes Грызуны Трихофития Trichophyton mentagrophytes var. quinckeanum Мышь Трихофития

Геофильные дерматофиты Виды дерматофитов Микозы Microsporum cookei Микроспория Microsporum gypseum Microsporum fulvum Microsporum nanum

эпидермофития стоп оп атлета начинается между пальцами ног, вызывая зуд, жжение и трещины в коже. Иногда повреждения затрагивают подошву и боковые части ноги, кожа становится толстой, жесткой на ощупь. Хотя общественные места и душевые считаются местом скопления грибковых инфекций, среда внутри обуви, возможно, играет даже большую роль. Встречается чаще с возрастом.



Грибковые инфекции ротовой полости и пищевода: Белый налёт во рту с ярко-красной слизистой и язвочками известен как «молочница» , или «афтозный стоматит» . Его причина – дрожжевой гриб Кандида. Молочница может распространяться на глотку и пищевод , вызывая появление болезненных язвочек. Дрожжевые грибки присутствуют в кишечнике каждого человека, и у 20% людей в общей популяции Кандида имеется и во рту, не вызывая никаких проблем.

Грибковые инфекции влагалища: Небольшие выделения из влагалища являются нормой; у некоторых женщин они более выражены, у некоторых – менее. На протяжении менструального цикла ситуация может меняться. Избыточные выделения, сопровождающиеся ощущением зуда, могут иметь различное происхождение. Они всегда вызваны нарушением баланса во влагалище, например, между бактериями, паразитами, грибами или вирусами. Основными причинами возникновения избыточных выделений может быть: • дисбаланс флоры влагалища, • грибы (Кандида), • трихомонады, • хламидии, • инородное тело во влагалище.

Причиной грибковых инфекций являются микроскопические микроорганизмы, которые становятся паразитами человеческого тела. Кожный грибок, типа плесени, вызывает такие заболевания, как нога атлета (трихофития стоп), зуд в области половых органов, стригущий лишай кожи головы. Кожные грибки этих типов живут на мертвых клетках головы, ногтей, и верхнего слоя кожи. Плохая гигиена, влажная кожа и незначительные заболевания кожи или ногтей увеличивают восприимчивость к грибковым инфекциям.

Современные системные антимикотики • • Амфотерицин В Флуконазол Интраконазол Кетоконазол Нистатин Тербинафин Гризеофульвин

Современные местные антимикотики • • • Нистатин Леворин Амфотерицин В Бифоназол Изоконазол Клотримазол Эконазол Тербинафин нитрофугин

возбудители грибковых инфекций.ppt